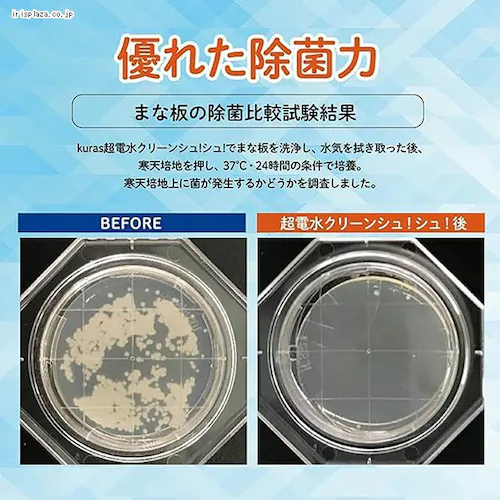
y2ZbgzdN[VIVIl 1100ml yvUZNgz_5

獲得予定ポイント
- 通常ポイント内訳
- お買い物ポイント
- 1倍
- 合計
- 24ポイント
※ポイントの獲得には会員ログインが必要です
- HOME
- イベント
- 日用品
- べビサポ会員対象ページ
- べビサポ会員【日用品】対象商品
- 【2個セット】超電水クリーンシュ!シュ!詰替 1100ml 【プラザセレクト】
商品をシェアする
【2個セット】超電水クリーンシュ!シュ!詰替 1100ml 【プラザセレクト】
リンクをコピーしました。
【2個セット】超電水クリーンシュ!シュ!詰替 1100ml 【プラザセレクト】
- ¥2,400(税込)
- 24ポイント
- (1倍)
水を電気分解して作られた「アルカリイオン水100%の除菌洗浄水」。アルコール不使用の為、火のそばや車の中でも使えます。
アルカリイオン水100%だから、二度拭き不要。拭き残りは水と同様に蒸発します。界面活性剤を含まない為、環境を汚しません。
通常の水よりも浸透力が強く、汚れの細部にまでしみこみ、汚れを浮き上がらせます。
この1本で洗浄と除菌が同時にできます。さらに消臭効果!
赤ちゃんやペットのいるご家庭にもオススメです。
不純物・添加物ゼロなので長期保管が可能!
超電水クリーンシュ!シュ!500ml本体に詰替えてお使いください。
アルカリイオン水100%だから、二度拭き不要。拭き残りは水と同様に蒸発します。界面活性剤を含まない為、環境を汚しません。
通常の水よりも浸透力が強く、汚れの細部にまでしみこみ、汚れを浮き上がらせます。
この1本で洗浄と除菌が同時にできます。さらに消臭効果!
赤ちゃんやペットのいるご家庭にもオススメです。
不純物・添加物ゼロなので長期保管が可能!
超電水クリーンシュ!シュ!500ml本体に詰替えてお使いください。
もっと見る
※製品は予告なく仕様を変更する場合がございます。あらかじめご了承ください。
●商品サイズ(cm)
幅約10×奥行約6.2×高さ約22
●内容量
1100ml×2
●成分
電解アルカリ水100%
| JAN |
4933691969997
|
|---|
レビューはまだ投稿されていません。お客様のレビューをお待ちしています
※当商品はお取り寄せ品の為、在庫の確認及び商品のお届けまでお時間を頂く場合がございます。
また、商品がメーカーにて完売となっていた場合、キャンセル又は注文内容の変更をお願いいたしております。
予めご了承くださいますようお願いいたします。 ■こちらの商品はアイリスプラザがセレクトしたオススメ商品です。
また、商品がメーカーにて完売となっていた場合、キャンセル又は注文内容の変更をお願いいたしております。
予めご了承くださいますようお願いいたします。 ■こちらの商品はアイリスプラザがセレクトしたオススメ商品です。

在庫切れ